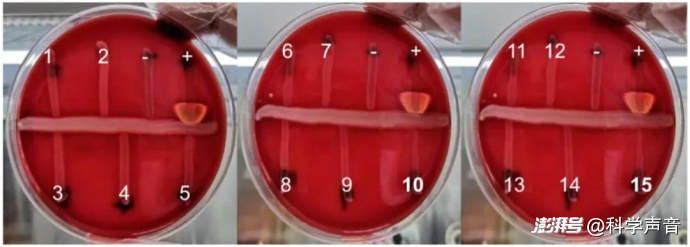

- +1
國(guó)產(chǎn)首款痤瘡疫苗要來(lái)了,“月球臉”終于有救了?
“近日,威斯克生物聯(lián)合四川大學(xué)華西醫(yī)院自主研發(fā)的痤瘡治療性疫苗,正式獲得中國(guó)國(guó)家藥品監(jiān)督管理局(NMPA)新藥臨床試驗(yàn)申請(qǐng)(IND)批準(zhǔn),成為中國(guó)首款進(jìn)入臨床階段的痤瘡治療性疫苗?!?/p>
很多聽眾朋友說(shuō)自己的臉常年跟“月球表面”似的,各種藥膏、藥片沒(méi)少用,錢也沒(méi)少花,就是斷不了根。

祛痘成功的美女小姐姐(與文中疫苗無(wú)關(guān),僅展示祛痘能達(dá)到的美容效果) 圖源:Depositphotos 商業(yè)授權(quán)
現(xiàn)在這個(gè)國(guó)產(chǎn)“戰(zhàn)痘疫苗”拿到臨床試驗(yàn)許可了,是不是意味著,以后一針下去,所有臉部問(wèn)題就都解決了?
大家先別急著激動(dòng),這種心情我特別理解。不過(guò),按照咱們的老規(guī)矩,在相信一個(gè)“好消息”之前,我們得先用科學(xué)精神把它扒拉透了。你只有先搞明白青春痘這東西為什么這么難纏,才能回頭看懂手里的各種“武器”——不管是藥膏、口服藥、醫(yī)美,還是那個(gè)萬(wàn)眾期待的“疫苗”——到底是在干什么,它們的邊界又在哪里。
一、你的臉為什么會(huì)變成“油田”和“戰(zhàn)場(chǎng)”?
很多人一長(zhǎng)痘,第一反應(yīng)就是“昨晚沒(méi)睡好”或者“肯定是那頓火鍋吃壞了”。這些有沒(méi)有關(guān)系?有一點(diǎn)關(guān)系,但它們最多算個(gè)導(dǎo)火索。咱們得知道,青春痘,學(xué)名叫痤瘡,它不是什么“上火”,而是在你毛囊里發(fā)生的一場(chǎng)多方參與的“局部戰(zhàn)爭(zhēng)”。
你可以把每個(gè)毛囊想象成一個(gè)“小型石油加工廠”,故事通常分四步:
第一階段,“原油”開采過(guò)剩:青春期,你體內(nèi)的雄激素一發(fā)號(hào)施令,皮脂腺就開始瘋狂加班生產(chǎn)皮脂,T 字區(qū)尤其油光锃亮。

動(dòng)圖釋義:皮脂腺(sebaceous gland)“生產(chǎn)”皮脂(sebum)
第二階段,“出口”堵塞:毛囊口的角質(zhì)細(xì)胞不知道怎么回事,該退休的不退休,賴在門口不走,把路堵死了。油出不去,就憋在了里面。

動(dòng)圖釋義:毛孔(pore)被堵塞
第三階段,“當(dāng)?shù)鼐用瘛睌?shù)量失控:每個(gè)人的毛囊里,都住著一種常駐細(xì)菌叫“痤瘡丙酸桿菌”。本來(lái)它挺安分的,但現(xiàn)在油又多又沒(méi)氧氣,環(huán)境太舒服了,它們就開始瘋狂繁殖,還到處排泄一些會(huì)引發(fā)麻煩的代謝產(chǎn)物。細(xì)菌加代謝產(chǎn)物的作亂,形成了痤瘡。

動(dòng)圖釋義:各方力量形成毛孔堵塞(clogged pore),引發(fā)痤瘡(acne)
第四階段,“火警系統(tǒng)”拉響:你身體的免疫系統(tǒng)就像個(gè)超級(jí)靈敏的火警探測(cè)器,一檢測(cè)到這些細(xì)菌產(chǎn)物,警報(bào)立刻拉滿,派出大量的炎癥因子去現(xiàn)場(chǎng)。于是,紅腫、疼痛的痘痘就冒出來(lái)了。要是這場(chǎng)火拼得太猛,傷到了真皮層,那痘坑可就留下了。

動(dòng)圖釋義:細(xì)菌(bacteria)引發(fā)炎癥(inflammation) 圖源:Acne: Understanding the Types of Acne and Treatment
一句話總結(jié):痤瘡是一場(chǎng)“油多+路堵+菌多+瞎發(fā)火”四個(gè)環(huán)節(jié)環(huán)環(huán)相扣的慢性病。
二、咱們手里的“老牌武器”,情況如何?
知道了原理,你再看手頭現(xiàn)有的這些治療方法,就像在分析一場(chǎng)多環(huán)節(jié)事故的解決方案:
外用藥(維 A 酸、過(guò)氧化苯甲酰等):這相當(dāng)于“現(xiàn)場(chǎng)搶修隊(duì)”,幫你通一下管道、壓制一下細(xì)菌、給炎癥滅滅火。對(duì)輕中度的痘痘管用,但可能會(huì)讓皮膚覺得干、受刺激。你要是長(zhǎng)期用抗生素藥膏,還得擔(dān)心耐藥性問(wèn)題。
口服藥(抗生素、異維A酸等):這就等于“系統(tǒng)級(jí)大修”了。抗生素能從內(nèi)部壓制細(xì)菌和炎癥,見效快,但副作用和耐藥風(fēng)險(xiǎn)得讓醫(yī)生好好評(píng)估。其中異維 A 酸更是個(gè)“王炸”,能同時(shí)搞定“減油、通路、抗炎”好幾個(gè)環(huán)節(jié),是目前對(duì)付重度痤瘡最有效的口服藥之一。
醫(yī)美手段(紅藍(lán)光、刷酸等):這更像是“戰(zhàn)后清障”,能幫你快速退紅、改善一下堵塞問(wèn)題。但它們改變不了你身體內(nèi)部的激素水平或者免疫反應(yīng)模式,所以該復(fù)發(fā)的還是可能復(fù)發(fā)。

動(dòng)圖釋義:所謂的“刷酸”(提示:醫(yī)美有風(fēng)險(xiǎn))圖源:皮膚管理 刷酸 ?????
你看,傳統(tǒng)治療就像是哪里出問(wèn)題就修哪里,但很難一次性把“油多、路堵、菌多、瞎發(fā)火”這四個(gè)環(huán)節(jié)全給它調(diào)成“低風(fēng)險(xiǎn)模式”。藥一停,只要你身體里那套程序沒(méi)變,痘痘就可能卷土重來(lái)。此時(shí),某些虛假?gòu)V告可能會(huì)跳出來(lái)號(hào)稱自己能“治本”,但要慢慢調(diào)理。于是調(diào)理三五年,正好趕上患者自然度過(guò)青春期,好把自愈的功勞據(jù)為己有,貪天之功了。
三、這個(gè)“戰(zhàn)痘疫苗”,思路到底新在哪?
這一次,科學(xué)家們換了個(gè)角度想問(wèn)題:除了“減油”和“控菌”,我們能不能勸勸免疫系統(tǒng),讓它別一接到警報(bào)就搞“大水漫灌”式的過(guò)度反應(yīng),而是能更精準(zhǔn)的打擊目標(biāo)?
這就是這次候選痤瘡治療性疫苗的核心思路。它不是我們平時(shí)打的那種預(yù)防感染的疫苗,而是希望在已經(jīng)長(zhǎng)痘的情況下,幫你減輕炎癥,降低復(fù)發(fā)風(fēng)險(xiǎn)。它瞄準(zhǔn)的是痤瘡丙酸桿菌分泌的一枚“毒素導(dǎo)彈”——CAMP 因子。疫苗把 CAMP 因子提純后做成抗原,讓身體提前產(chǎn)生“中和抗體”;下次細(xì)菌再釋放毒素,抗體就會(huì)像“反導(dǎo)系統(tǒng)”一樣精準(zhǔn)地把毒素直接中和掉,炎癥根本點(diǎn)不著火。換句話說(shuō),它既不幫你控油,也不幫你疏通毛孔,只是“拆掉了細(xì)菌點(diǎn)燃大規(guī)模炎癥的打火器”,從而讓免疫系統(tǒng)不至于過(guò)度反應(yīng)。
圖示:實(shí)驗(yàn)室中對(duì) 15 株細(xì)菌做的 CAMP 試驗(yàn)的檢測(cè)結(jié)果(針對(duì)無(wú)乳鏈球菌) 圖源:Analysis of molecular
這里順便說(shuō)一句,這種疫苗的生產(chǎn)過(guò)程會(huì)使用到基因工程技術(shù),打到身體里的是提純好的“蛋白質(zhì)”,跟咱們打了這么多年的乙肝疫苗、HPV 疫苗是一個(gè)路子,它不會(huì)改變?nèi)说幕?。而且食用轉(zhuǎn)基因食品也同樣不會(huì)改變?nèi)说幕颉?/p>
四、關(guān)鍵問(wèn)題:我到底什么時(shí)候能打上?
好,最關(guān)鍵的問(wèn)題來(lái)了。我得先給大家潑一盆冷水:未必能成,即便真行也早著呢。
要知道,一款新藥從研發(fā)到上市,平均要花十來(lái)年的時(shí)間,投入幾十億資金。新聞里說(shuō)的“拿到臨床試驗(yàn)申請(qǐng)批準(zhǔn)”,這好比你剛領(lǐng)到高考的準(zhǔn)考證,離拿到清華北大的錄取通知書還差得遠(yuǎn)呢。
疫苗上市通常要經(jīng)過(guò)三期臨床試驗(yàn):
I 期:幾十個(gè)健康人身上試試,首先要看安不安全。
II 期:在幾百個(gè)真正的患者身上,摸索到底用多少劑量最有效。
III 期:需要成百上千的患者參與,跟現(xiàn)有最好的療法做對(duì)比,進(jìn)一步確認(rèn)它的安全性和有效性。
這三關(guān),任何一關(guān)過(guò)不了,整個(gè)項(xiàng)目都可能被叫停,而且最終過(guò)不了的可能性是不低的。即便都能過(guò),痤瘡畢竟不是什么致命的急癥,現(xiàn)在也有一定的治療方式可以代替。因此“戰(zhàn)痘疫苗”只是多提供了一條思路和路徑。所以藥監(jiān)局只會(huì)更加謹(jǐn)慎,而不會(huì)為了它大開綠燈加急。所以,即便一切順利,咱們能在 5 到 10 年后見到成品就不錯(cuò)了;如果中途發(fā)現(xiàn)抗原或者佐劑需要調(diào)整,那時(shí)間只會(huì)更長(zhǎng)。
所以,我給大家三條實(shí)實(shí)在在的建議:
第一,保持關(guān)注,真要治療就別干等。如果你現(xiàn)在正被痘痘嚴(yán)重困擾,最靠譜的做法是立刻、馬上去正規(guī)醫(yī)院皮膚科,在醫(yī)生指導(dǎo)下規(guī)范用藥、合理護(hù)膚。等幾年后疫苗上市,很可能你愛長(zhǎng)痘的“主戰(zhàn)期”都過(guò)去了。千萬(wàn)別因?yàn)橐粍t新聞耽誤了治療,更不要相信市面上任何號(hào)稱能提前打到“內(nèi)部針”的騙局。
第二,理解科學(xué)的進(jìn)程,別期待奇跡。科學(xué)研究就是這樣,充滿了未知和不確定性。這款疫苗可能成功,也可能失敗。但無(wú)論結(jié)果如何,它都為我們通過(guò)“免疫調(diào)節(jié)”來(lái)治療痤瘡提供了寶貴的新數(shù)據(jù)。我們應(yīng)該相信科學(xué)這套體系,它雖然慢,但它是我們解決問(wèn)題最可靠的路徑。
第三,心態(tài)放平,臉不是你的全部。外貌只是我們生命狀態(tài)的一小部分。有時(shí)候人們?cè)绞顷P(guān)注自己的某個(gè)點(diǎn),就越會(huì)覺得這個(gè)點(diǎn)就是全世界。其實(shí)完全可以放大視野,有時(shí)間多培養(yǎng)自己別的優(yōu)勢(shì)和愛好。把注意力轉(zhuǎn)移到一些更有意義的事上,這比天天只盯著鏡子里的瑕疵更有價(jià)值。
最后我想說(shuō),我很能理解長(zhǎng)痘人的煩惱。但科學(xué)有它自己的節(jié)奏,人生也有各自的節(jié)拍。我們能做的,就是在循證醫(yī)學(xué)的指導(dǎo)下打好眼前這場(chǎng)仗,同時(shí)給科學(xué),也給自己的未來(lái),都多留一點(diǎn)耐心和信心。
本文為澎湃號(hào)作者或機(jī)構(gòu)在澎湃新聞上傳并發(fā)布,僅代表該作者或機(jī)構(gòu)觀點(diǎn),不代表澎湃新聞的觀點(diǎn)或立場(chǎng),澎湃新聞僅提供信息發(fā)布平臺(tái)。申請(qǐng)澎湃號(hào)請(qǐng)用電腦訪問(wèn)http://renzheng.thepaper.cn。





- 報(bào)料熱線: 021-962866
- 報(bào)料郵箱: news@thepaper.cn
滬公網(wǎng)安備31010602000299號(hào)
互聯(lián)網(wǎng)新聞信息服務(wù)許可證:31120170006
增值電信業(yè)務(wù)經(jīng)營(yíng)許可證:滬B2-2017116
? 2014-2025 上海東方報(bào)業(yè)有限公司




